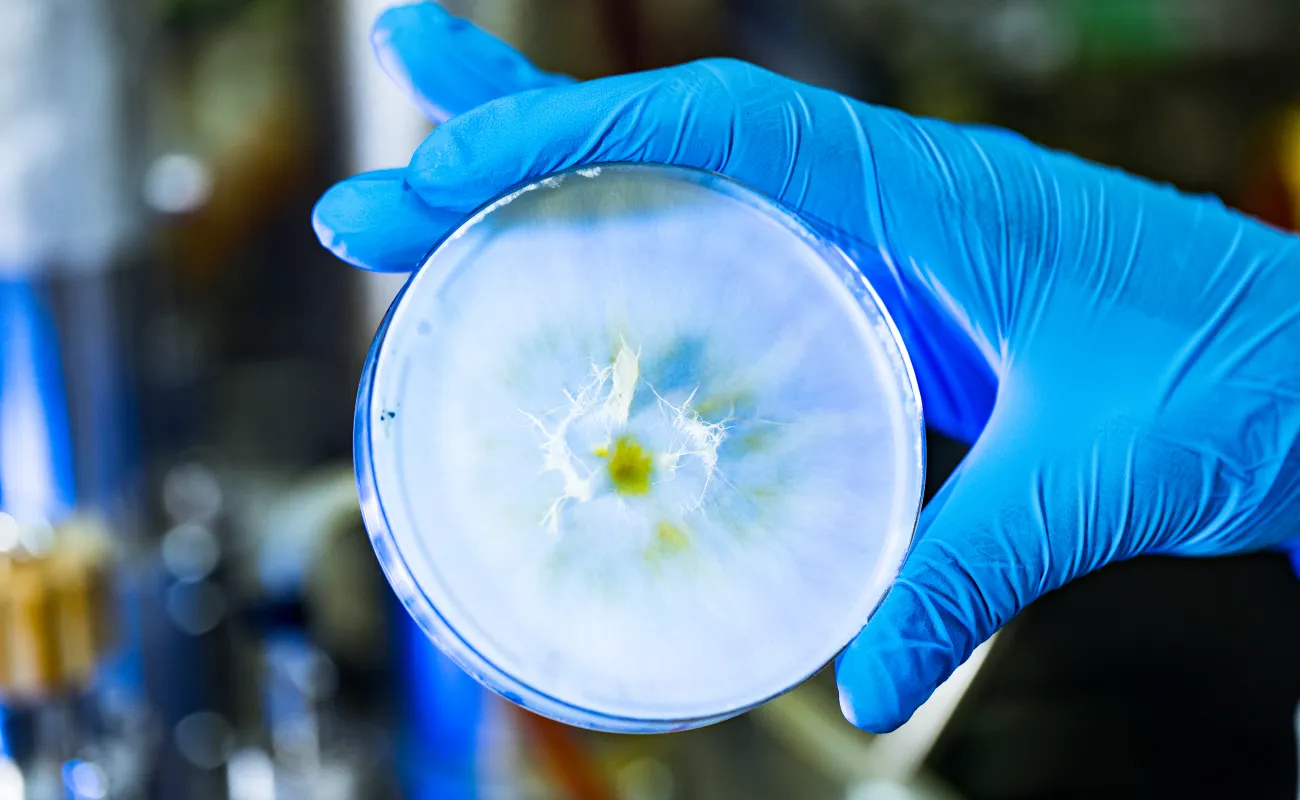
person looking at chemicals

What we do
Contact information:
Highlights
CSIR Biomanufacturing Programme elevates Africa’s GMP expertise
Twenty-seven participants from across Africa recently celebrated their graduation after completing an intensive Biomanufacturing and Good Manufacturing Practice (GMP) course as part of the CSIR’s African Biomanufacturing Workforce Development and Training Programme. Read more.
Fungal protein for food security
The CSIR has developed a sustainable bioprocess to manufacture a fungal-based protein product for a South African biotechnology company called MycoSure. The starting material for the mycoprotein is Fusarium venenatum – a fungus known for its high protein content. CSIR researchers have developed a production process to make this protein in a bioreactor, offering several sustainability and cost advantages over livestock and crop-based protein production. This is the first time that this specific fungal protein production is applied in Africa. Watch.
Skills development for African vaccine manufacturing target
The CSIR has trained 151 researchers and scientists from across Africa to help build African capacity for the manufacturing of biologics, vaccines, recombinant proteins and therapeutics. The training was part of the CSIR’s African Biomanufacturing Workforce Training and Skills Development Programme. Courses in biomanufacturing technologies, vaccine production and biopharmaceutical quality management systems were offered during 2023, 2024 and 2025. Watch.
CSIR develops protein for commercial fishing industry
The CSIR assisted Ziziba (Pty) Ltd, a small, medium and micro enterprise, with a scalable biobased technology to produce single-cell protein that is used as an ingredient in fish feed. The CSIR’s single-cell protein prototype is produced using a fungal-based biorefinery process that exploits industrial food waste streams as essential feedstocks during the synthesis of single-cell protein.
Our capabilities
We pioneer sustainable bio-based manufacturing by leveraging biological systems to create innovative, cost-effective technologies and products. With scalable infrastructure and deep technical expertise, we accelerate the journey from lab-scale discovery to commercial implementation, empowering industry with market-ready, environmentally responsible solutions.
Our facilities